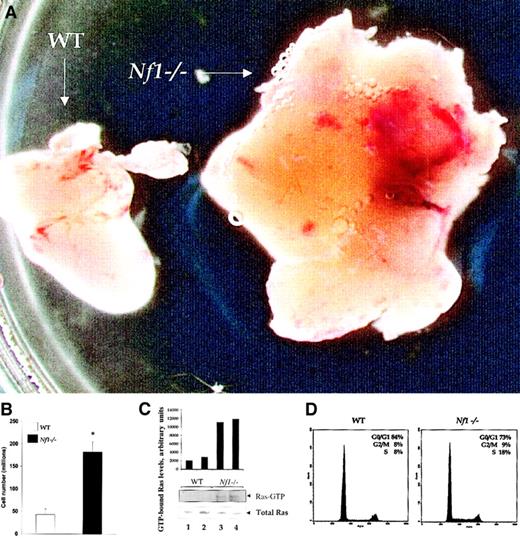
Fig. 2. Nf1 homozygosity results in thymic hyperplasia. / (A) Size comparison between WT and Nf1−/− thymi. RAG2−/− mice that received equal numbers of WT orNf1−/− fetal liver or bone marrow hematopoietic stem and progenitor cells and were killed 2 to 3 months after transplantation. Shown is a representative WT andNf1−/− thymus from a total of 16 analyzed. Original magnification, × 10. (B) Quantitative comparison of thymic cellularity in RAG2−/− mice that received WT and Nf1−/− fetal liver or bone marrow cells. Single cell suspensions from WT andNf1−/− thymi were prepared and counted. Bars represent the absolute numbers of thymocytes (± SEM) from 13 different mice. * P < .001. (C) Ras activity of freshly isolated WT (lanes 1,2) and Nf1−/− (lanes 3,4) thymocytes. GTP-bound Ras levels were determined by incubating cell lysates with Raf-1 RBD conjugated to agarose beads and by immunoblotting with an anti-Ras antibody. Immunoblots and quantitative densitometry for Ras-GTP levels and Western blot for total Ras from 2 separate WT and Nf1−/− mice are shown. (D) Cell cycle analysis of WT and Nf1−/−thymocytes shown in (A). Single cell suspensions from WT andNf1−/− thymi were stained with propidium iodide and analyzed by flow cytometry, and the percentage of cells from different phases of cell cycle is shown.

Ras plays an essential role in lymphocyte development and function. However, in vivo consequence(s) of regulation of Ras activity by guanosine triphosphatase (GTPase)–activating proteins (GAPs) on lymphocyte development and function are not known. In this study we demonstrate that neurofibromin, the protein encoded by theNF1 tumor suppressor gene functions as a GAP for Ras in T cells. Loss of Nf1 in T cells results in enhanced Ras activation, which is associated with thymic and splenic hyperplasia, and an increase in the absolute number of immature and mature T-cell subsets compared with control mice. Interestingly, in spite of a profound T-cell expansion and higher thymidine incorporation in unstimulated Nf1-deficient T cells, T-cell receptor and interleukin-2 receptor–mediated proliferation of thymocytes and mature T cells was substantially reduced compared with control mice. Collectively, these results identify neurofibromin as a GAP for Ras in T cells for maintaining immune homeostasis in vivo.
Introduction
In lymphocytes, engagement of antigen and cytokine receptors results in the activation of multiple signaling pathways. The simultaneous activation of these pathways enhances the efficient transcription of genes encoding cytokines and cytokine receptors, necessary for further activation, proliferation, and maturation of lymphocytes.1 One of these signaling pathways involves the activation of a small GTPase, Ras. Ras is rapidly activated in antigen and cytokine receptor-stimulated lymphocytes, resulting in the activation of multiple downstream effector pathways, including transcription factors, involved in cytokine gene induction and development of T and B cells.1
The guanine nucleotide binding cycle of Ras is controlled by guanine nucleotide exchange factors (GEFs) that promote the transition from the guanosine diphosphate (GDP)–bound state to the active guanosine triphosphate (GTP)–bound conformation. This effect is reversed by GTPase-activating proteins (GAPs), which stimulate intrinsic Ras GTPase activity, resulting in hydrolysis of bound GTP to GDP and the accumulation of inactive GDP-Ras complexes.2-5 In developing thymocytes, genetic studies have shown that the GEFs, RasGRP, and the Sos-binding protein Grb2 regulate Ras activity in vivo. Inactivation of either RasGRP or Grb2 in mice by homologous recombination results in impaired T-cell development and function because of reduced activation of Ras and its downstream effectors.6,7 However, substantial differences in the thymic phenotype exist between RasGRP and Grb2-deficient mice. RasGRP mice show a 25% reduction in thymic cellularity compared with control mice. They have substantially reduced single-positive (SP) thymocytes. Spleens of these animals contain relatively few mature T cells, consistent with reduced numbers of SP T cells in the thymus. Impaired T-cell development in RasGRP mice is also associated with reduced proliferation and activation of Ras-GTP and extracellular signal-related kinase (ERK) activity in response to T-cell receptor (TCR) stimulation.6 In contrast, Grb2 haploinsufficiency does not affect ERK activity; instead, it attenuates p38 and c-Jun NH2-terminal kinase (JNK) activity in response to TCR stimulation. These biochemical alterations are associated with reduced ability of thymocytes to undergo negative, but not positive, selection.7 Thus, although loss of RasGRP and Grb2 haploinsufficiency in thymocytes results in reduced Ras-GTP, the biologic and biochemical alterations downstream from Ras are quite different. The role of specific GAPs in maintaining overall Ras activity, and consequently the development and function of lymphocytes, has not been investigated. At least 2 GAPs, p120 GAP (also known as Ras-GAP) and neurofibromin (the protein encoded by the Nf1gene), regulate Ras output in mammalian cells5,8-11 by promoting the conversion of Ras-GTP to Ras-GDP.5 However, their specific role in regulating Ras activity in lymphocytes in vivo is unknown.
Mutations of NF1 cause neurofibromatosis type 1 (NF1), an autosomal-dominant disorder with an incidence of 1 in 4000.10-14 Affected individuals are predisposed to the development of benign and malignant neoplasms that arise primarily in cells derived from the embryonic neural crest.10-15Genetic and biochemical studies have demonstrated that NF1functions as a tumor suppressor gene by negatively regulating Ras signaling.16-20 Mice that are heterozygous for a targeted disruption of Nf1 (Nf1+/−) are predisposed to a number of cancers, including myeloid leukemia.21,22 Leukemic cells from many of these animals show loss of the normal Nf1 allele.21,22Although mice homozygous for disruption of Nf1 die during embryonic development, adoptive transfer ofNf1−/− fetal liver cells into irradiated wild-type (WT) recipients reconstitutes hematopoiesis and results in a myeloproliferative defect.23,24 Further, we have recently shown that Nf1-deficient stem cells demonstrate a growth advantage not only of myeloid cells but also of lymphoid cells in a competitive repopulation assay,25 suggesting a potential role for neurofibromin in lymphocyte development and function. Although substantial recent effort has been made toward understanding the role of Ras in lymphocyte development and function, relatively little is known about the role of GAPs in these processes.
In the present study, we have examined the biochemical and functional consequence(s) of Nf1 deficiency in T-cell development and function. We demonstrate that Nf1 deficiency in T cells results in increased thymic and splenic cellularity and an increase in the number of cells in each major T-cell subset. This is associated with impaired proliferation in response to T-cell receptor (TCR) and interleukin-2 receptor (IL-2R) stimulation in vitro. Biochemically,Nf1 deficiency results in elevated basal Ras-GTP levels. In summary, these data demonstrate that neurofibromin functions as a critical negative regulator of Ras and T-cell homeostasis in vivo.
Materials and methods
Animals
Nf1+/− mice were obtained from Dr T. Jacks at the Massachusetts Institute of Technology (Cambridge, MA) in a C57BL/6.129 background and were backcrossed for 13 generations into the C57BL/6J strain. C57BL/6J–recombination activating gene-2 (RAG2)–deficient mice were purchased from Jackson Laboratories (Bar Harbor, ME). These studies were conducted with a protocol approved by the Indiana University Laboratory Animal Research Center.
Flow cytometric analysis
Phycoerythrin (PE)–conjugated and fluorescein isothiocyanate (FITC)– conjugated monoclonal antibodies (mAbs) against T-cell specific markers, including CD4, CD8, and CD3, were purchased from Invitrogen (Grand Island, NY). Thymocytes and splenocytes were harvested by using standard procedures. Single-cell suspensions were prepared, and 1 × 106 cells of each genotype were incubated at 4°C for 30 minutes with various antibodies. Cells were washed 3 times with phosphate-buffered saline (PBS) containing 0.1% bovine serum albumin (BSA; Sigma), incubated with the second antibody for 30 minutes at 4°C, washed as above, and analyzed by a fluorescence-activated cell sorter (FACS; Becton Dickinson, San Jose, CA).
Generation of Nf1−/−T cells
Heterozygous C57BL/6J Nf1+/− mice were mated to produce Nf1+/+,Nf1+/−, and Nf1−/−embryos. Pregnant Nf1+/− female mice were killed by cervical dislocation on day 13.5 of gestation, and the embryos were removed and genotyped as previously described.26 Low-density fetal liver cells (5-10 × 106) from Nf1+/+ andNf1−/− littermates were transplanted into syngenic C57BL/6J-RAG2−/− recipient mice conditioned with 400 rads of gamma irradiation from Cs source (Gamma cell 40 Extractor; MDS Nordion Kanata, Ontario, Canada) as previously described to facilitate reconstitution.27 In some experiments low-density WT and Nf1−/− bone marrow (BM) cells derived from stably reconstituted adult animals withNf1−/− and Nf1+/+ fetal liver cells from embryonic day 13.5 were transplanted into RAG2−/− mice. In previous studies, we have demonstrated that hematopoietic stem and progenitor cells (HSPs) derived from the BM of adult mice stably reconstituted with Nf1−/−fetal liver cells function similar to fetal liver-derivedNf1−/− HSPs following transplantation into irradiated WT recipients.25,26 RAG2−/−recipients were killed 2 to 3 months after transplantation as reported previously.27 Spleen and thymus were harvested to compare functional and biochemical consequences of complete loss ofNf1 in thymocytes and mature T cells.
In vitro proliferation of T cells
To examine the in vitro proliferative capacity ofNf1+/+, Nf1+/−, andNf1−/− T cells, thymocytes, splenocytes (2 × 105 cells per well), and purified T cells (1 × 105 cells per well) were stimulated with indicated concentrations (see figure legends for detail) of anti-CD3 (145-2C11; Pharmingen/BD, San Diego, CA) mAb. T cells were purified from spleens of various mice according to manufacturer's instructions (R & D systems, Minneapolis, MN). Briefly, single-cell suspensions were prepared from spleen; red cells were lysed using red cell lysis buffer and resuspended in wash buffer. Cells were then subjected to a T-cell enrichment column and eluted according to the manufacturer's instructions. Purified T cells (1 × 105) were placed in a round-bottom 96-well plate in Iscove modified Dulbecco medium (IMDM) with 10% fetal calf serum (FCS) and 10−5 M β-mercaptoethanol. T cells were stimulated by using plate-bound anti-CD3 mAb and/or interleukin-2 (IL-2) (R & D Systems). Forty-eight hours later cells were pulsed with 1 μCi [3H] thymidine (Amersham Pharmacia Biotech) and harvested 12 hours later to determine the amount of incorporated thymidine.
Ras activation assay
Freshly isolated thymocytes were lysed in nonionic lysis buffer (20 mM Tris (tris(hydroxymethyl)aminomethane)/HCl, 137 mM NaCl, 1 mM EGTA (ethyleneglycoltetraacetic acid), 1% Triton X-100, 10% glycerol, 1.5 mM MgCl2) and complete protease inhibitors (Amersham Pharmacia Biotech). The protein lysates were equalized for protein concentration by using bicinchoninic acid (BCA) assay (Pierce Chemical), and equal loading of protein in these assays was confirmed by Western blot. Ras activation was subsequently determined by using a Ras activation kit (Upstate Biotechnology) according to the manufacturer's protocol and as previously described.28
Results
Nf1 heterozygosity results in increased basal Ras activity, thymic cellularity, T-cell subset distribution in vivo, but reduced thymocyte proliferation in vitro
Although neurofibromin functions as a GAP for Ras in myeloid cells,23 24 its GAP activity in T cells has not been investigated. To determine whether neurofibromin functions as a GAP for Ras in these cells in vivo, we measured Ras-GTP levels in freshly isolated (unstimulated) thymocytes from WT andNf1+/− mice. As shown in Figure1A, Nf1+/−thymocytes demonstrate increased Ras-GTP levels compared with WT control mice.
Biochemical and functional analysis of WT and
Nf1+/− thymocytes. (A) Ras activity of freshly isolated WT (lane 1) and Nf1+/−(lane 2) thymocytes. GTP-bound Ras levels were determined by incubating cell lysates with Raf-1 Ras binding domain (RBD) conjugated to agarose beads and by immunoblotting with an anti-Ras antibody. Immunoblots and quantitative densitometry for Ras-GTP levels and Western blots of total Ras are shown. (B) Thymic cellularity of WT andNf1+/− mice. Single cell suspensions from WT and Nf1+/− thymi were prepared and counted. Bars represent the absolute numbers of thymocytes (± SEM), n = 12 and * P < .0004. (C) T-cell subset distribution of WT and Nf1+/− thymi. Bars represent the absolute numbers of indicated T-cell subsets (± SEM), n = 12 and * P < .004. (D) Immunocytometric analysis of thymocytes from WT and Nf1+/− mice. Thymocytes from WT andNf1+/− mice were stained with fluorochrome-conjugated antibodies directed against the indicated cell surface proteins and analyzed by flow cytometry. Data are representative of 5 independent experiments. (E) Altered proliferation of Nf1+/− thymocytes. Thymocytes (105/well) were isolated and activated with plate-bound anti-CD3 mAb, IL-2, or anti-CD3 mAb plus IL-2. Proliferation was measured by a thymidine incorporation assay. Bars denote the mean thymidine incorporation (cpm ± SEM) of a representative experiment performed in replicates of 6. * P < .01Nf1+/− versus WT. ** P < .01Nf1+/− versus WT.
Biochemical and functional analysis of WT and
Nf1+/− thymocytes. (A) Ras activity of freshly isolated WT (lane 1) and Nf1+/−(lane 2) thymocytes. GTP-bound Ras levels were determined by incubating cell lysates with Raf-1 Ras binding domain (RBD) conjugated to agarose beads and by immunoblotting with an anti-Ras antibody. Immunoblots and quantitative densitometry for Ras-GTP levels and Western blots of total Ras are shown. (B) Thymic cellularity of WT andNf1+/− mice. Single cell suspensions from WT and Nf1+/− thymi were prepared and counted. Bars represent the absolute numbers of thymocytes (± SEM), n = 12 and * P < .0004. (C) T-cell subset distribution of WT and Nf1+/− thymi. Bars represent the absolute numbers of indicated T-cell subsets (± SEM), n = 12 and * P < .004. (D) Immunocytometric analysis of thymocytes from WT and Nf1+/− mice. Thymocytes from WT andNf1+/− mice were stained with fluorochrome-conjugated antibodies directed against the indicated cell surface proteins and analyzed by flow cytometry. Data are representative of 5 independent experiments. (E) Altered proliferation of Nf1+/− thymocytes. Thymocytes (105/well) were isolated and activated with plate-bound anti-CD3 mAb, IL-2, or anti-CD3 mAb plus IL-2. Proliferation was measured by a thymidine incorporation assay. Bars denote the mean thymidine incorporation (cpm ± SEM) of a representative experiment performed in replicates of 6. * P < .01Nf1+/− versus WT. ** P < .01Nf1+/− versus WT.
To investigate the biologic consequence(s) of elevated basal Ras-GTP levels in thymocytes derived from Nf1+/− mice, T-cell development, thymic cellularity, and T-cell maturation were examined and compared with WT mice by using mAbs that recognize T-cell–specific markers unique to different stages of T-cell maturation. As shown in Figure 1B, Nf1+/−mice demonstrate a modest but a substantial increase in thymic cellularity compared with WT control animals. Further, the absolute number of CD4+CD8+ double-positive (DP), CD4+ and CD8+ single-positive (SP), and CD4−CD8− double-negative (DN) T-cell subsets were also marginally but substantially elevated inNf1+/− mice compared with WT control mice (Figure 1C). However, the differentiation of DN thymocytes to DP and SP thymocytes was similar between WT and Nf1+/−mice (Figure 1D). Further, the expression of TCR-CD3 complex as determined by anti-CD3 mAb staining was also similar between WT andNf1+/− thymocytes (Figure 1D). Thus, elevated basal Ras-GTP levels in Nf1+/− thymocytes result in a marginal but a substantial increase in thymic cellularity and specific thymocyte subsets, without substantially affecting differentiation/maturation as determined by the expression of CD4, CD8, and CD3 cell surface proteins.
To determine the effect of elevated basal Ras-GTP levels on the proliferation of Nf1+/− thymocytes in vitro, we examined thymidine incorporation in WT andNf1+/− thymocytes in response to IL-2 and TCR stimulation. As shown in Figure 1E, stimulation ofNf1+/− thymocytes by anti-CD3 mAb cross-linking of the TCR resulted in proliferation but significantly less compared with WT controls. This decrease was also observed in response to IL-2 stimulation (Figure 1E). Combined stimulation via the T cell and the IL-2 receptor substantially enhanced proliferation in both WT andNf1+/− thymocytes. However, the increase was less apparent in Nf1+/− thymocytes compared with controls. Interestingly, in spite of the reduced proliferation noted in response to TCR and IL-2R stimulation inNf1+/− thymocytes, baseline (unstimulated) proliferation of these cells was substantially higher than WT controls. These results suggest that, although TCR- and IL-2R–mediated proliferation is reduced in Nf1+/− thymocytes in vitro, neurofibromin expression is essential for regulating steady state (baseline) proliferation and/or survival of thymocytes in vivo.
Nf1 deficiency results in increased thymic cellularity and T-cell subset numbers in vivo but reduced proliferation in vitro
Because intercrossing of Nf1+/− mice to produce Nf1-deficient mice results in midgestation embryonic lethality because of cardiac failure, precluding a direct analysis of the consequences of Nf1 deficiency on lymphocyte development and function, RAG2-deficient mice receivedNf1−/− fetal liver or BM derived stem/progenitor cell transplants to directly asses the role ofNf1 deficiency on T-cell development and function in vivo. In pilot experiments, we determined that the phenotype observed in RAG2−/− mice that receivedNf1−/− BM cells from stably reconstituted adult mice was similar to that observed withNf1−/− fetal liver cells (data not shown). Therefore, in most experiments we used Nf1−/−low-density BM cells for transplantation into RAG2−/− mice.
In RAG2-deficient mice thymocyte development is arrested at the transition from the CD3−CD4−CD8−to the CD3−/low CD4+CD8+stage,29,30 causing a lack of mature peripheral T cells. This developmental defect can be overcome by introducing WT hematopoietic progenitors in either genetically chimeric mice31 or fetal liver or BM chimera.27Therefore, RAG2−/− mice have been used as a model to study the function of genes that result in mid to late gestation embryonic lethality but are thought to otherwise play an essential role in the development and function of lymphocytes, including T and B cells. As shown in Figure 2A-B,Nf1 deficiency results in significantly greater thymic cellularity compared with control mice. Further, the increase in thymic cellularity was associated with elevated basal Ras-GTP levels (Figure2C) and an increase in the percentage of thymocytes in the “S” phase of cell cycle (Figure 2D). Consistent with the increase in the number of cells in different T-cell subsets noted inNf1+/− mice, Nf1 deficiency also resulted in a profound increase in the absolute number of cells in different T-cell subsets, including DP, SP, and DN (Figure3A). This increase in the absolute number of cells in different T-cell subsets was associated with reduced apoptosis in response to concanavalin A (ConA) stimulation but not dexamethasone or irradiation (data not shown). Interestingly, complete loss of Nf1 did not impair the maturation/differentiation of DN thymocytes to DP and SP subsets as measured by the expression of CD4, CD8, and CD3 (Figure 3B). Taken together, these results demonstrate that neurofibromin does not play a crucial role in regulating T-cell maturation in vivo.
Nf1 homozygosity results in thymic hyperplasia.
(A) Size comparison between WT and Nf1−/− thymi. RAG2−/− mice that received equal numbers of WT orNf1−/− fetal liver or bone marrow hematopoietic stem and progenitor cells and were killed 2 to 3 months after transplantation. Shown is a representative WT andNf1−/− thymus from a total of 16 analyzed. Original magnification, × 10. (B) Quantitative comparison of thymic cellularity in RAG2−/− mice that received WT and Nf1−/− fetal liver or bone marrow cells. Single cell suspensions from WT andNf1−/− thymi were prepared and counted. Bars represent the absolute numbers of thymocytes (± SEM) from 13 different mice. * P < .001. (C) Ras activity of freshly isolated WT (lanes 1,2) and Nf1−/− (lanes 3,4) thymocytes. GTP-bound Ras levels were determined by incubating cell lysates with Raf-1 RBD conjugated to agarose beads and by immunoblotting with an anti-Ras antibody. Immunoblots and quantitative densitometry for Ras-GTP levels and Western blot for total Ras from 2 separate WT and Nf1−/− mice are shown. (D) Cell cycle analysis of WT and Nf1−/−thymocytes shown in (A). Single cell suspensions from WT andNf1−/− thymi were stained with propidium iodide and analyzed by flow cytometry, and the percentage of cells from different phases of cell cycle is shown.
Nf1 homozygosity results in thymic hyperplasia.
(A) Size comparison between WT and Nf1−/− thymi. RAG2−/− mice that received equal numbers of WT orNf1−/− fetal liver or bone marrow hematopoietic stem and progenitor cells and were killed 2 to 3 months after transplantation. Shown is a representative WT andNf1−/− thymus from a total of 16 analyzed. Original magnification, × 10. (B) Quantitative comparison of thymic cellularity in RAG2−/− mice that received WT and Nf1−/− fetal liver or bone marrow cells. Single cell suspensions from WT andNf1−/− thymi were prepared and counted. Bars represent the absolute numbers of thymocytes (± SEM) from 13 different mice. * P < .001. (C) Ras activity of freshly isolated WT (lanes 1,2) and Nf1−/− (lanes 3,4) thymocytes. GTP-bound Ras levels were determined by incubating cell lysates with Raf-1 RBD conjugated to agarose beads and by immunoblotting with an anti-Ras antibody. Immunoblots and quantitative densitometry for Ras-GTP levels and Western blot for total Ras from 2 separate WT and Nf1−/− mice are shown. (D) Cell cycle analysis of WT and Nf1−/−thymocytes shown in (A). Single cell suspensions from WT andNf1−/− thymi were stained with propidium iodide and analyzed by flow cytometry, and the percentage of cells from different phases of cell cycle is shown.
Nf1 homozygosity results in increased thymic T-cell subset numbers but reduced T-cell receptor–mediated proliferation.
(A) Comparison of cells in each major T-cell subset between WT cells transplanted into RAG2−/− mice (WT→RAG2−/−) and Nf1−/− cells transplanted into RAG2−/− mice (Nf1−/−→RAG2−/−) thymus. Bars represent the absolute numbers of indicated T-cell subsets (± SEM), n = 13 and * P < .001. (B) Immunocytometric analysis of thymocytes from WT→RAG2−/− andNf1−/−→RAG2−/− mice. Cells were stained with fluorochrome-conjugated antibodies directed against the indicated cell surface proteins and analyzed by flow cytometry. Data are representative of 5 independent experiments with similar results. (C) Reduced proliferation of Nf1−/−thymocytes. Thymocytes (105/well) were isolated and activated with plate-bound anti-CD3 mAb or anti-CD3 mAb plus IL-2. Proliferation was measured by thymidine incorporation assay. Bars denote the mean thymidine incorporation (cpm ± SEM) of a representative experiment performed in replicates of 6. * P < .01 Nf1−/− versus WT. ** P < .01 Nf1−/− versus WT.
Nf1 homozygosity results in increased thymic T-cell subset numbers but reduced T-cell receptor–mediated proliferation.
(A) Comparison of cells in each major T-cell subset between WT cells transplanted into RAG2−/− mice (WT→RAG2−/−) and Nf1−/− cells transplanted into RAG2−/− mice (Nf1−/−→RAG2−/−) thymus. Bars represent the absolute numbers of indicated T-cell subsets (± SEM), n = 13 and * P < .001. (B) Immunocytometric analysis of thymocytes from WT→RAG2−/− andNf1−/−→RAG2−/− mice. Cells were stained with fluorochrome-conjugated antibodies directed against the indicated cell surface proteins and analyzed by flow cytometry. Data are representative of 5 independent experiments with similar results. (C) Reduced proliferation of Nf1−/−thymocytes. Thymocytes (105/well) were isolated and activated with plate-bound anti-CD3 mAb or anti-CD3 mAb plus IL-2. Proliferation was measured by thymidine incorporation assay. Bars denote the mean thymidine incorporation (cpm ± SEM) of a representative experiment performed in replicates of 6. * P < .01 Nf1−/− versus WT. ** P < .01 Nf1−/− versus WT.
To determine whether Nf1−/− thymocytes functionally respond to cytokine or antigen receptor stimulation in vitro, we stimulated WT and Nf1−/− thymocytes with either IL-2 or anti-CD3 mAb as described in “Materials and methods.” Consistent with the reduced proliferation ofNf1+/− thymocytes in response to IL-2 and anti-CD3 mAb, in vitro stimulation of Nf1−/−thymocytes with anti-CD3 mAb is paralleled by a substantial decrease in proliferation compared with controls (Figure 3C). Further, similar to Nf1+/− thymocytes, baseline (unstimulated) proliferation of Nf1−/−thymocytes was also substantially higher compared with controls. These results suggest that expression of Nf1 is essential for regulating steady state (baseline) proliferation and/or survival of thymocytes in vivo.
Nf1 deficiency results in increased splenic cellularity and T-cell numbers
To determine whether the enhanced thymic cellularity inNf1−/− mice also results in elevated numbers of mature T cells in the periphery, we compared the spleens of RAG2−/− mice that received either WT orNf1−/− cells. As shown in Figure 4A-B, RAG2−/− mice that received Nf1−/− fetal liver or BM cells demonstrated splenomegaly and a significant increase in the number of mature T-cell subsets, including CD4 and CD8 SP T cells without affecting differentiation/maturation of these cells (Figure 5A-B). Taken together, these data demonstrate that neurofibromin plays an essential role in the regulation of both mature T-cell numbers in the periphery and immature T-cells numbers in the thymus without affecting differentiation/maturation.
Nf1 homozygosity results in splenic hyperplasia.
(A) Comparison of splenic size between WT and Nf1−/− mice. RAG2−/− mice received equal numbers of WT orNf1−/− fetal liver or bone marrow hematopoietic stem and progenitor cells and were killed 2 to 3 months after transplantation. Shown are representative WT andNf1−/− spleens from a total of 7 analyzed with similar results. Original magnification, × 10. (B) Quantitative comparison of splenic cellularity in RAG2−/− mice that received WT andNf1−/− fetal liver or bone marrow cells. Single cell suspensions from WT and Nf1−/−spleens were prepared and counted. Bars represent the absolute numbers of splenocytes (± SEM) from a total of 7 mice of each type. * P < .0005.
Nf1 homozygosity results in splenic hyperplasia.
(A) Comparison of splenic size between WT and Nf1−/− mice. RAG2−/− mice received equal numbers of WT orNf1−/− fetal liver or bone marrow hematopoietic stem and progenitor cells and were killed 2 to 3 months after transplantation. Shown are representative WT andNf1−/− spleens from a total of 7 analyzed with similar results. Original magnification, × 10. (B) Quantitative comparison of splenic cellularity in RAG2−/− mice that received WT andNf1−/− fetal liver or bone marrow cells. Single cell suspensions from WT and Nf1−/−spleens were prepared and counted. Bars represent the absolute numbers of splenocytes (± SEM) from a total of 7 mice of each type. * P < .0005.
Nf1 homozygosity results in an elevated number of mature T cells in the spleen without altering differentiation.
(A) Comparison of CD4 and CD8 SP T-cell numbers between WT→RAG2−/− andNf1−/−→RAG2−/− spleen. Bars represent the absolute numbers of indicated T-cell subsets (± SEM), n = 7 and * P < .0007. (B) Immunocytometric analysis of splenocytes from RAG2−/− (did not receive transplants), WT→RAG2−/−, andNf1−/−→RAG2−/− mice. Splenocytes were stained with fluorochrome-conjugated antibodies directed against the indicated cell surface proteins and analyzed by flow cytometry. Data are representative of 3 independent experiments with similar results.
Nf1 homozygosity results in an elevated number of mature T cells in the spleen without altering differentiation.
(A) Comparison of CD4 and CD8 SP T-cell numbers between WT→RAG2−/− andNf1−/−→RAG2−/− spleen. Bars represent the absolute numbers of indicated T-cell subsets (± SEM), n = 7 and * P < .0007. (B) Immunocytometric analysis of splenocytes from RAG2−/− (did not receive transplants), WT→RAG2−/−, andNf1−/−→RAG2−/− mice. Splenocytes were stained with fluorochrome-conjugated antibodies directed against the indicated cell surface proteins and analyzed by flow cytometry. Data are representative of 3 independent experiments with similar results.
Reduced proliferation in Nf1−/−splenocytes and purified T cells
To determine whether phenotypically matureNf1−/− T cells proliferate in response to T-cell–specific mitogens, splenocytes and purified T cells from the spleens of WT and Nf1−/− mice were stimulated in vitro with anti-CD3 mAb, either alone or in combination with IL-2. As shown in Figure 6A-B and consistent with the reduced proliferation noted above in thymocytes derived from Nf1+/− andNf1−/− mice, mature T cells fromNf1−/− mice are also substantially impaired in their ability to incorporate thymidine in response to TCR and IL-2R stimulation. Further, similar to the results observed usingNf1+/− and Nf1−/−thymocytes, baseline (unstimulated) proliferation inNf1−/− splenocytes and purified T cells was also marginally but substantially higher compared with controls. These data demonstrate that in spite of relatively normal T-cell maturation in the periphery, neurofibromin deficiency results in impaired in vitro proliferation in response to T-cell–specific mitogens.
Reduced T-cell receptor–mediated proliferation in
Nf1−/− splenic T cells. Splenocytes (A) or purified T cells (2 × 105/well) (B) were isolated and activated with plate-bound anti-CD3 mAb or anti-CD3 mAb plus IL-2. Proliferation was measured by thymidine incorporation assay. Bars denote the mean thymidine incorporation (cpm ± SEM) of a representative experiment performed in replicates of 6. ** P < .01 Nf1−/− versus WT.
Reduced T-cell receptor–mediated proliferation in
Nf1−/− splenic T cells. Splenocytes (A) or purified T cells (2 × 105/well) (B) were isolated and activated with plate-bound anti-CD3 mAb or anti-CD3 mAb plus IL-2. Proliferation was measured by thymidine incorporation assay. Bars denote the mean thymidine incorporation (cpm ± SEM) of a representative experiment performed in replicates of 6. ** P < .01 Nf1−/− versus WT.
Discussion
Little is known about the role of neurofibromin in lymphocytes, although neurofibromin is expressed in these cells and is redistributed in response to cross-linking of surface immunoglobulin.32Further, overexpression of N-Ras in Nf1+/− mice increases the incidence of lymphomas compared with mice carrying a single lesion of either N-Ras or Nf1.33Additionally, altered immune homeostasis has been described in a patient with a mutation in the NF1 gene.34 More recently, by using a competitive repopulation assay we have demonstrated that Nf1-deficient stem cells show a growth advantage not only in the myeloid lineage but also in the lymphoid lineage.25 However, these studies did not investigate the role of NF1 in the development and function of various T-cell subsets. In the present study, by usingNf1+/− mice and lymphocyte-deficient RAG2−/− mice that receivedNf1−/− hematopoietic cells, we have examined the consequence(s) of inactivating one or 2 alleles of Nf1in T-cell development and function. We show that neurofibromin regulates T-cell homeostasis in vivo, which is associated with increased basal Ras activity.
The use of RAG2−/− mice, but not lethally irradiated mice, offers the advantage that the former do not depend on hematopoietic stem cell transfer for their survival because nonlymphocyte lineages are not affected by the mutation. Further, in the absence of competition from endogenous lymphocyte precursors, RAG2−/−-recipient mice provide a sensitive in vivo system to study lymphopoiesis from hematopoietic precursors. By using these mice, our results demonstrate that loss of Nf1 results in a lymphoproliferative defect both in immature and mature T-cell compartments. This defect is associated with elevated levels of basal Ras-GTP in developing thymocytes, identifying neurofibromin as a mammalian GAP for Ras in T cells. Although novel with respect to T cells, previous studies have clearly shown that NF1regulates myeloid cell proliferation, in part by regulating Ras activity.23,24 Specifically, hematopoietic progenitors derived from patients with NF1, or mice lacking the expression ofNf1 are hypersensitive to granulocyte-macrophage colony-stimulating factor (GM-CSF) and stem cell factor (SCF), which is associated with elevated levels of basal Ras-GTP.23-26 Consistent with a role for NF1function as a GAP for Ras in myeloid cells, expression of the GAP-related domain of NF1 in Nf1−/−hematopoietic cells is sufficient to correct the hypersensitivity to growth factors associated with these cells in vitro.35
The observation that neurofibromin regulates decreased induced proliferation in thymocytes is consistent with previous studies comparing Ras-GTP levels in embryonic cell lines derived from mice deficient in the expression of p120-GAP or neurofibromin.36 The p120-GAP mutant cell lines from E9.5 embryos are more sensitive than WT cells to growth factor-induced changes in Ras-GTP levels.36 In contrast,Nf1-deficient E9.5 embryonic cell lines do not demonstrate a substantial increase in Ras-GTP levels in response to growth factor stimulation but exhibit a higher basal level of Ras-GTP.36These results suggest that p120-GAP may function to down-regulate Ras molecules that have been activated by growth factor receptors, whereas neurofibromin may play an essential role in regulating basal Ras-GTP levels.36,37 Consistent with these findings, p120-GAP−/− and Nf1−/− mouse embryos have distinct phenotypes. Embryos homozygous for both mutations have a phenotype much more severe than that seen by either mutation alone,37 suggesting that p120-GAP and neurofibromin may have independent biologic functions but synergize to regulate Ras output.37
Consistent with several reports that demonstrate altered biologic responses in multiple cell types because of loss of one Nf1allele,38-45 loss of a single Nf1 allele was also sufficient in modulating Ras activity in unstimulated thymocytes, which correlated with a modest but a substantial increase in T-cell subset numbers in Nf1+/− mice. The increase in the T-cell subset numbers was, however, more apparent in thymocytes and splenocytes lacking the expression of both Nf1 alleles. Interestingly, despite the increase in the total number of thymocytes in Nf1+/− and Nf1−/−mice in vivo, stimulation of these cells via the TCR and/or the IL-2 receptor resulted in a substantial decrease in proliferation in vitro, although the proliferation of unstimulatedNf1+/− and Nf1−/− T cells was substantially higher compared with WT controls. The reason for this apparent paradox is unclear, although similar lymphoproliferative defects have been reported in other systems. Specifically, mice deficient in the expression of IL-2Rβ or Stat5a/b develop a lymphoproliferative defect similar to that observed inNf1−/− mice.46,47 T cells in Stat5a/b- and IL-2Rβ–deficient mice develop normally; however, they fail to proliferate in vitro in response to IL-2 and TCR cross-linking.46,47 Interestingly, both IL-2Rβ– and Stat5a/b-deficient mice also develop splenomegaly, similar to that observed in Nf1−/− mice. The lack of proliferation in Stat5a/b-deficient mice is due to lack of induction of expression of cell cycle–related genes in response to TCR and IL-2R stimulation.46 Whether similar defects exist inNf1−/− T cells needs to be investigated.
Several studies have suggested a role for Ras and its downstream effectors in regulating T-cell development and function, including Raf, mitogen-induced extracellular kinase (MEK), and ERK.48-53 However, most of these studies used dominant-negative and/or activated forms of kinases.48-52Although informative, these studies do not clearly reflect the physiologic consequence(s) of altered Ras activity on T-cell development and function in vivo. In the present study, we show thatNf1 deficiency results in increased numbers of immature and mature T cells in vivo, which is associated with reduced in vitro proliferation in response to TCR and IL-2R stimulation. This phenotype correlates with elevated basal Ras activity. To our knowledge these are the first studies describing the in vivo and in vitro consequences of impaired GAP activity on T-cell development and function.
We thank Drs Merv Yoder and Mark Kaplan for their helpful discussions and suggestions on the manuscript. We thank Marsha Hippensteel for her help with manuscript preparation.
Prepublished online as Blood First Edition Paper, July 5, 2002; DOI 10.1182/blood-2002-03-0734.
Supported by the National Institutes of Health grant R29 CA74177 (D.W.C.), Department of Defense grant NF000035 (D.W.C.), and by the National Institute of Health Pediatric Scientist Development Program Grant K12-HD0050 (D.A.I.). R.K. is a recipient of the American Society of Hematology Junior Faculty Scholar Award.
The publication costs of this article were defrayed in part by page charge payment. Therefore, and solely to indicate this fact, this article is hereby marked “advertisement” in accordance with 18 U.S.C. section 1734.
References
Note added in proof
Kim et al54 recently reported a similar reduction inNf1−/− B lymphocytes and thymocyte proliferation in vitro.
Author notes
Reuben Kapur, Herman B. Wells Center for Pediatric Research, Cancer Research Bldg, 1044 W Walnut St, Rm 425, Indianapolis, IN 46202; e-mail: rkapur@iupui.edu.